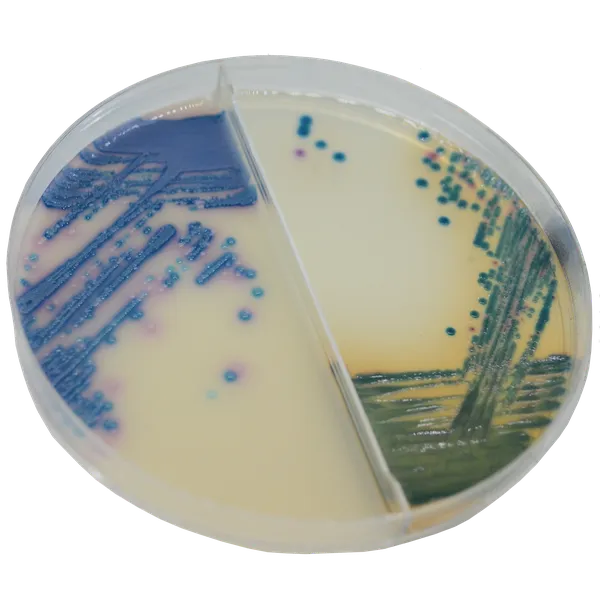
CHROMagar™ Mastitis

Hình thái khuẩn lạc

CHROMagar™ Mastitis GP
S. agalactiae

CHROMagar™ Mastitis GP
S. uberis

CHROMagar™ Mastitis GP
S. aureus

CHROMagar™ Mastitis GN
Klebsiella, Enterobacter, Citrobacter

CHROMagar™ Mastitis GN
E. coli

CHROMagar™ Mastitis GN
Proteus

CHROMagar™ Mastitis GN
C. albicans
Hiệu năng
Hiệu năng
Việc không kiểm soát sự lây lan của viêm vú ở gia súc được biết đến là nguyên nhân gây tổn thất kinh tế nặng nề cho người sản xuất sữa và ngành công nghiệp sữa. Viêm vú gây ra giảm về số lượng và chất lượng sản lượng sữa, tăng chi phí thú y do sử dụng thuốc quá mức, tăng nguy cơ tồn dư thuốc trong sữa hoặc thịt và do đó, có thể gây hại cho sức khỏe cộng đồng.
Chi phí ước tính cho mỗi lần nhiễm viêm vú cấp tính dao động từ $178 đến $489 tùy thuộc vào giá sữa, mức sản xuất của bò bị ảnh hưởng và giai đoạn tiết sữa khi bệnh xảy ra. Thực tế, nguyên nhân phổ biến nhất của việc sử dụng kháng sinh trong bò sữa là điều trị và phòng ngừa viêm vú.
Để tránh sử dụng kháng sinh một cách bừa bãi ở gia súc và giảm gánh nặng kinh tế của viêm vú cấp tính, việc xác định nhanh chóng tác nhân gây bệnh sữa ngay tại trang trại là vô cùng quan trọng.
CHROMagar™ Mastitis là một công cụ thương mại mới có sẵn để phân biệt nhanh chóng và đơn giản các vi khuẩn chính liên quan đến nhiễm khuẩn viêm vú. Nó được cung cấp dưới dạng bộ kit với hai môi trường khác nhau, một cho vi khuẩn gram dương và cái còn lại cho vi khuẩn gram âm.
1. Phân biệt màu sắc của các vi khuẩn gây bệnh chính : Tạo điều kiện lựa chọn liệu pháp phù hợp và tối ưu.
2. Phát hiện trong 24 giờ : Giảm thiểu thời gian ra quyết định điều trị tốt nhất.
3. Đĩa hai trong một : Cho phép nhận diện toàn bộ phổ vi khuẩn Gram (+) và Gram (-) chỉ trong một cái nhìn.
Thành phần

Tài liệu kỹ thuật
Công bố khoa học
2021
Evaluation of chromogenic culture media for rapid identification of microorganisms isolated from cows with clinical and subclinical mastitis
? Publication2021
Evaluation of Chromogenic culture media for rapid identification of gram-positive bacteria causing mastitis
? Publication2022
3D-Printed Dip Slides Miniaturize Bacterial Identification and Antibiotic Susceptibility Tests Allowing Direct Mastitis Sample Analysis
? Publication

Xem thêm